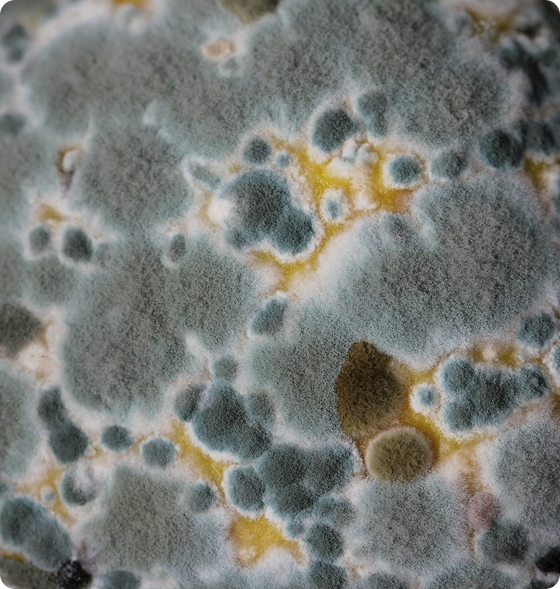

Cleaner Air Has Never Been This Easy

1 Year Warranty
365-nights backed by safety + comfort

Pay as you go
Buy-now, pay-later financing @ 0% APR

Fast, Free Shipping
2-5 day shipping in the continental US

30-Day Home Trial
The best air you've ever had, guaranteed

24-hour Customer Service
Real, US-based customer support
How do Air Purifiers solve for Mold?
Mold releases tiny spores into the air, which can linger and easily be inhaled, leading to a range of health concerns. These microscopic spores can trigger allergic reactions, exacerbate respiratory conditions, and even cause long-term health complications for individuals with weakened immune systems.
Air purifiers can prevent mold growth, reducing the colonization of mold by preventing airborne spores from settling on surfaces where they could grow and spread.
Airdog air purifiers are built to particles as small as 0.0146 microns with 99.99% efficiency, which is much smaller than typical mold spores that range from 2-100 microns. Unlike traditional HEPA filters that simply trap particles, Airdog's TPA technology actively destroys mold spores by generating a high-voltage electrostatic field that kills bacteria, viruses, and mold rather than just collecting them.

Air Purifiers
Airdog engineers the most reliable, most effective air purifiers in the world with a unit designed for every space.
Find the right purifiers your offices, your family spaces, bedrooms and more.
Mold, Tough Gunk Meet Their Match Read More
The Hidden Mold Problem in Modern Homes
Mold spores are present in virtually every indoor environment, but modern homes with improved insulation and reduced ventilation create ideal conditions for mold growth and spore concentration. Areas with even minimal moisture—like bathrooms, basements, kitchens, and around windows—can harbor mold colonies that continuously release microscopic spores into your air supply. These spores can remain airborne for hours, circulating through HVAC systems and settling throughout your home, creating widespread exposure even in rooms that appear mold-free.
How Mold Spores Affect Your Health and Home
Mold spores are potent allergens and irritants that can trigger respiratory symptoms, skin reactions, and serious health issues in sensitive individuals, with some species producing toxic compounds called mycotoxins that pose additional health risks. Unlike other allergens, mold spores can actually germinate and grow inside your respiratory system if conditions are right, potentially leading to fungal infections in immunocompromised individuals. The musty odors associated with mold growth are often the first sign of a problem, but by the time you smell mold, spore levels in your air may already be dangerously high.
Why Traditional Filtration Falls Short Against Mold
Most mold spores range from 1-20 microns in size, which means standard HEPA filters can capture many of them, but the smallest and most problematic spores—including those from toxic black mold species—can be as small as 0.3 microns or smaller, right at the edge of HEPA efficiency. Additionally, captured mold spores can continue to grow and reproduce within moist HEPA filters, potentially turning your air purifier into a mold distribution system if filters aren't replaced frequently. This is particularly concerning because many people don't realize their filters have become contaminated until their symptoms actually worsen.
The Year-Round Nature of Indoor Mold Exposure
Unlike seasonal allergens, mold exposure is a constant threat because indoor mold growth occurs year-round, with humidity levels, temperature changes, and moisture from daily activities like cooking and showering providing continuous opportunities for spore production. Winter months can be particularly problematic as heating systems circulate stagnant air and condensation from temperature differences creates hidden moisture problems in walls and around windows. Even homes without visible mold problems can have elevated spore counts that cause ongoing health issues, making effective air filtration essential for anyone sensitive to mold or living in humid climates.
Don’t Just Take Our Word For It
Check out why people love AirdogLet me be the first to tell you that this gadget is amazing! ... I can rest assured knowing that the garbage in the air is ending up on that filter and not lingering around for me to breathe all night. I can report that I've had no sinus infections since owning the Airdog which have plagued my existence. Its impact on my quality of life has been immeasurable."
"We started with the purchase of a X8 Air Purifier for our living area and were amazed with results. We noticed that our allergies became almost non-existent and the normal kitchen odors that used to permeate the house after cooking a meal no longer lingered."
"For the first time in a while, the kids don't wake in the morning all coughs and sneezes. We are no longer taking any allergy medication. ... Thanks to the X8, we are finally dealing with the cause and not just our symptoms."
"This is the best air filter I've had. I'm in love with it. ... Due to cat dandruff, I have a hard time breathing. It is hard for me to sleep at night but since getting the X5, I am sleeping all night now and breathing through my nose again."
"My family is breathing so much better inside now—no more coughing, we sleep better at night, and even the pets seem to be more comfortable now."
"My LIFE depends on this Airdog X3. I am 75 years old and was told I have numerous allergies and would be needing a sleep apnea machine. ... I am allergy- and pill-free, no need for a sleep apnea machine, all my tests are perfect. Most of all, I BREATHE the MOST BEAUTIFUL FRESH AIR possible."

Order your Airdog Now
Frequently Asked Questions - Air Purifiers for Mold, Bacteria, & Beyond
How do Airdog air purifiers handle mold spores and mold growth?
Do Airdog air purifiers need replacement filters like traditional HEPA purifiers?
Are Airdog purifiers effective in improving indoor air quality?
Which Airdog model should I choose based on room size?
How do Airdog purifiers compare to HEPA air purifiers?
Are these purifiers safe to use around kids and pets?
What causes mold odors, and can Airdog help?
How often do I need to clean the filters?
Can Airdog purifiers remove more than just mold?
Do Airdog air purifiers include smart features or remote control?